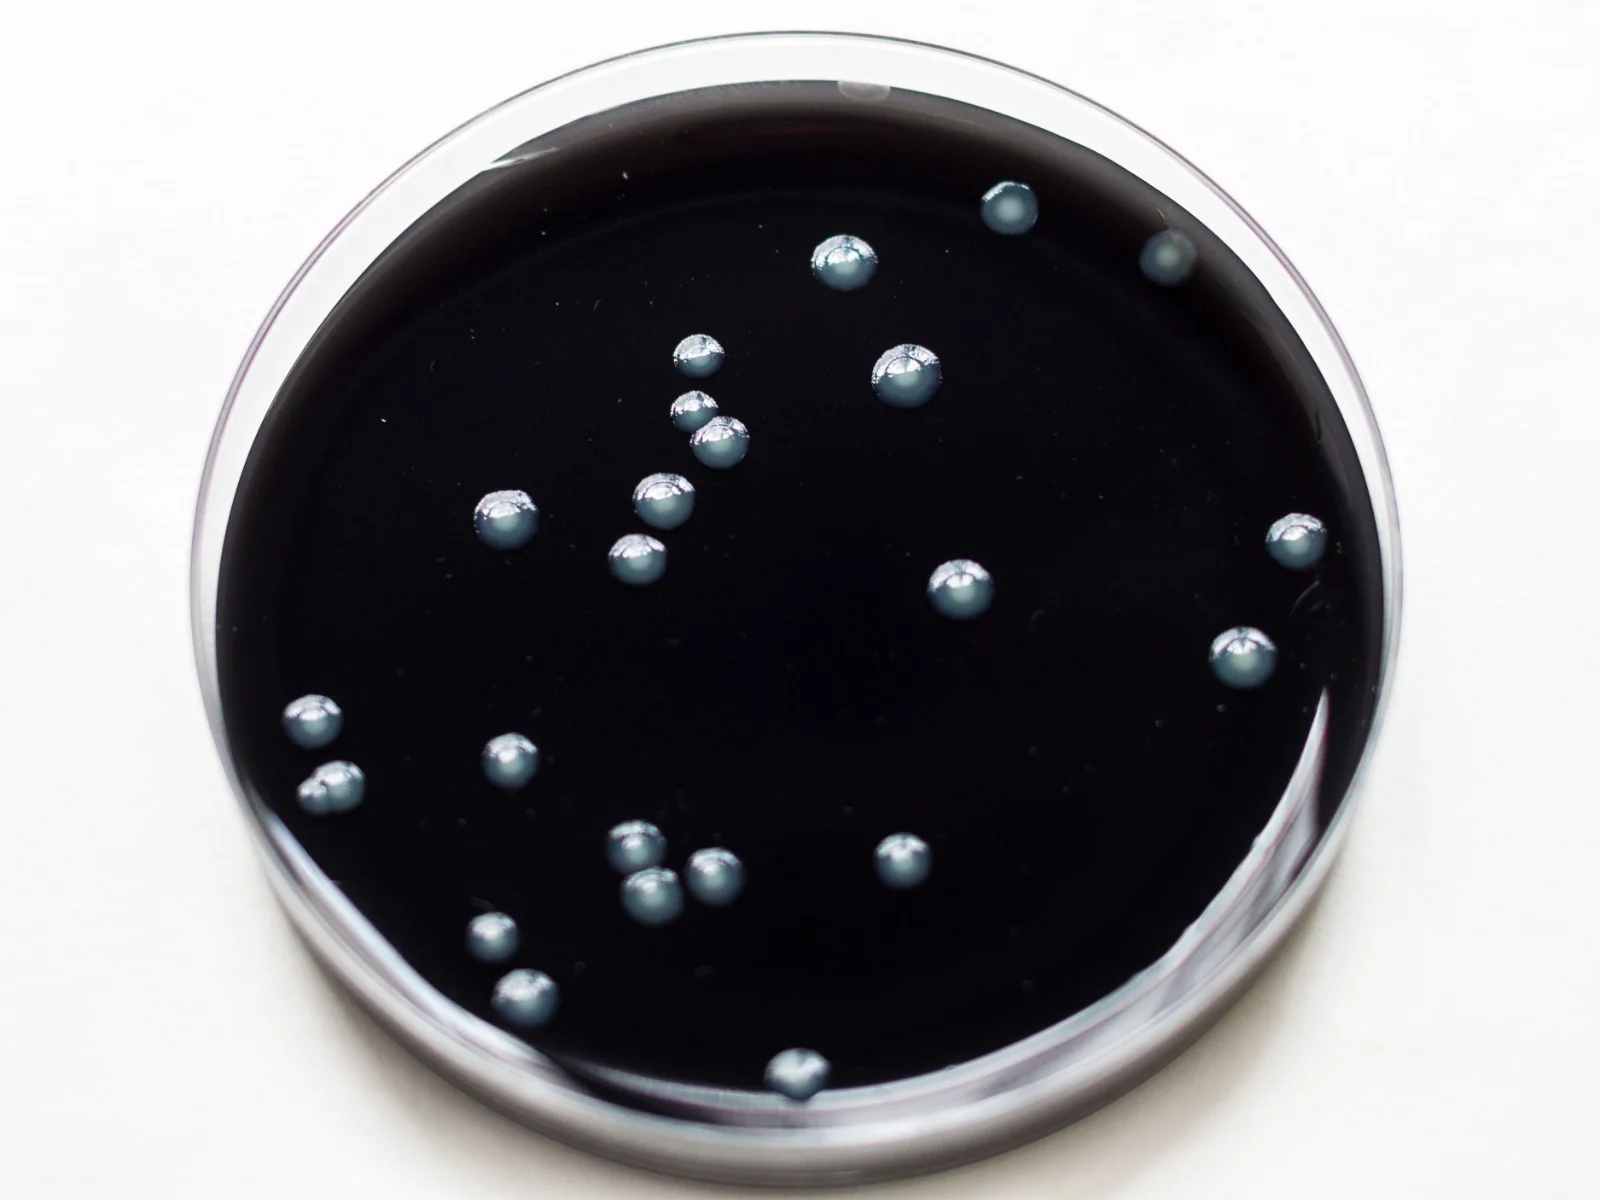
placa de análisis legionella

Legionella
LABORATORIOS NICB S.L. ofrece a sus clientes el control y prevención de legionella.
Control y prevención de legionella según RD 865/2003
Tratamientos certificados para garantizar la seguridad hídrica de tus instalaciones
Si está interesado en este servicio, póngase en contacto con nosotros para poder realizar una visita a sus instalaciones y prepararle un presupuesto sin compromiso, de acuerdo a la instalación que tenga.
Realizamos limpieza y desinfección de:
Empresa inscrita en el ROESBA con número de registro 0181-AND-550